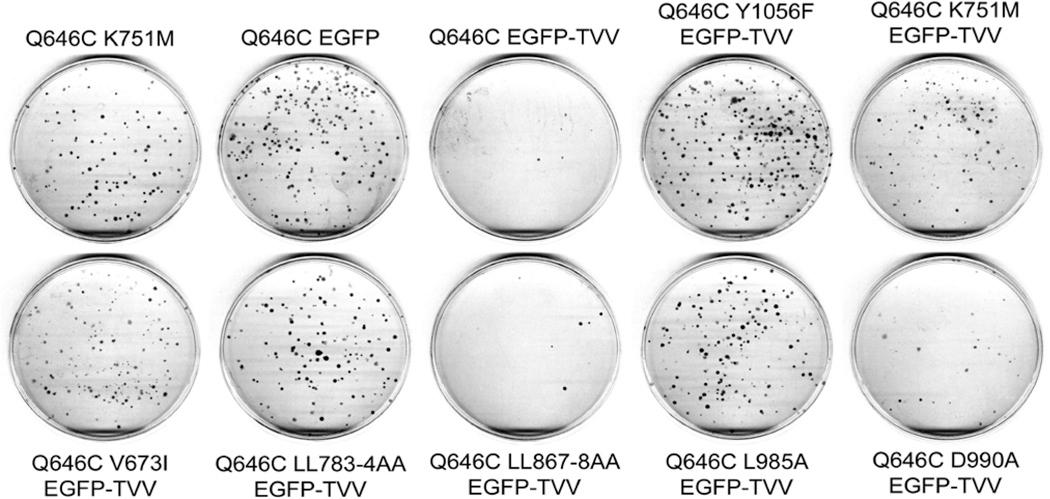
https://cdn.ncbi.nlm.nih.gov/pmc/blobs/8a2b/4002051/328875868d5c/nihms562629f6.jpg

组成型激活的ErbB4突变体的肿瘤抑制活性需要多种功能基序。
Multiple Functional Motifs Are Required for the Tumor Suppressor Activity of a Constitutively-Active ErbB4 Mutant.
作者信息
Gallo Richard M, Bryant Ianthe N, Mill Christopher P, Kaverman Steven, Riese David J
机构信息
Department of Medicinal Chemistry and Molecular Pharmacology, Purdue University College of Pharmacy & Purdue University Center for Cancer Research, West Lafayette, IN 47907, USA ; Department of Microbiology and Immunology, Indiana University School of Medicine, Indianapolis, IN 46206 USA.
Department of Medicinal Chemistry and Molecular Pharmacology, Purdue University College of Pharmacy & Purdue University Center for Cancer Research, West Lafayette, IN 47907, USA.
出版信息
J Cancer Res Ther Oncol. 2013 Aug 22;1(1):10.
ErbB4 (HER4) is a member of the ErbB family of receptor tyrosine kinases, which includes the Epidermal Growth Factor Receptor (EGFR/ErbB1), ErbB2 (HER2/Neu), and ErbB3 (HER3). Mounting evidence indicates that ErbB4, unlike EGFR or ErbB2, functions as a tumor suppressor in many human malignancies. Previous analyses of the constitutively-dimerized and -active ErbB4 Q646C mutant indicate that ErbB4 kinase activity and phosphorylation of ErbB4 Tyr1056 are both required for the tumor suppressor activity of this mutant in human breast, prostate, and pancreatic cancer cell lines. However, the cytoplasmic region of ErbB4 possesses additional putative functional motifs, and the contributions of these functional motifs to ErbB4 tumor suppressor activity have been largely underexplored. Here we demonstrate that ErbB4 BH3 and LXXLL motifs, which are thought to mediate interactions with Bcl family proteins and steroid hormone receptors, respectively, are required for the tumor suppressor activity of the ErbB4 Q646C mutant. Furthermore, abrogation of the site of ErbB4 cleavage by gamma-secretase also disrupts the tumor suppressor activity of the ErbB4 Q646C mutant. This last result suggests that ErbB4 cleavage and subcellular trafficking of the ErbB4 cytoplasmic domain may be required for the tumor suppressor activity of the ErbB4 Q646C mutant. Indeed, here we demonstrate that mutants that disrupt ErbB4 kinase activity, ErbB4 phosphorylation at Tyr1056, or ErbB4 cleavage by gamma-secretase also disrupt ErbB4 trafficking away from the plasma membrane and to the cytoplasm. This supports a model for ErbB4 function in which ErbB4 tumor suppressor activity is dependent on ErbB4 trafficking away from the plasma membrane and to the cytoplasm, mitochondria, and/or the nucleus.
ErbB4(HER4)是受体酪氨酸激酶ErbB家族的成员之一,该家族还包括表皮生长因子受体(EGFR/ErbB1)、ErbB2(HER2/Neu)和ErbB3(HER3)。越来越多的证据表明,与EGFR或ErbB2不同,ErbB4在许多人类恶性肿瘤中起着肿瘤抑制因子的作用。先前对组成型二聚化且具有活性的ErbB4 Q646C突变体的分析表明,在人乳腺癌、前列腺癌和胰腺癌细胞系中,该突变体的肿瘤抑制活性既需要ErbB4激酶活性,也需要ErbB4 Tyr1056位点的磷酸化。然而,ErbB4的胞质区域还具有其他假定的功能基序,而这些功能基序对ErbB4肿瘤抑制活性的贡献在很大程度上尚未得到充分研究。在此,我们证明,ErbB4的BH3和LXXLL基序,分别被认为介导与Bcl家族蛋白和类固醇激素受体的相互作用,是ErbB4 Q646C突变体肿瘤抑制活性所必需的。此外,γ-分泌酶对ErbB4切割位点的消除也会破坏ErbB4 Q646C突变体的肿瘤抑制活性。最后的这一结果表明,ErbB4的切割以及ErbB4胞质结构域的亚细胞转运可能是ErbB4 Q646C突变体肿瘤抑制活性所必需的。事实上,在此我们证明,破坏ErbB激酶活性、ErbB4 Tyr1056位点磷酸化或γ-分泌酶对ErbB4的切割的突变体,也会破坏ErbB4从质膜向细胞质的转运。这支持了一种ErbB4功能模型,即ErbB4肿瘤抑制活性依赖于ErbB4从质膜向细胞质、线粒体和/或细胞核的转运。